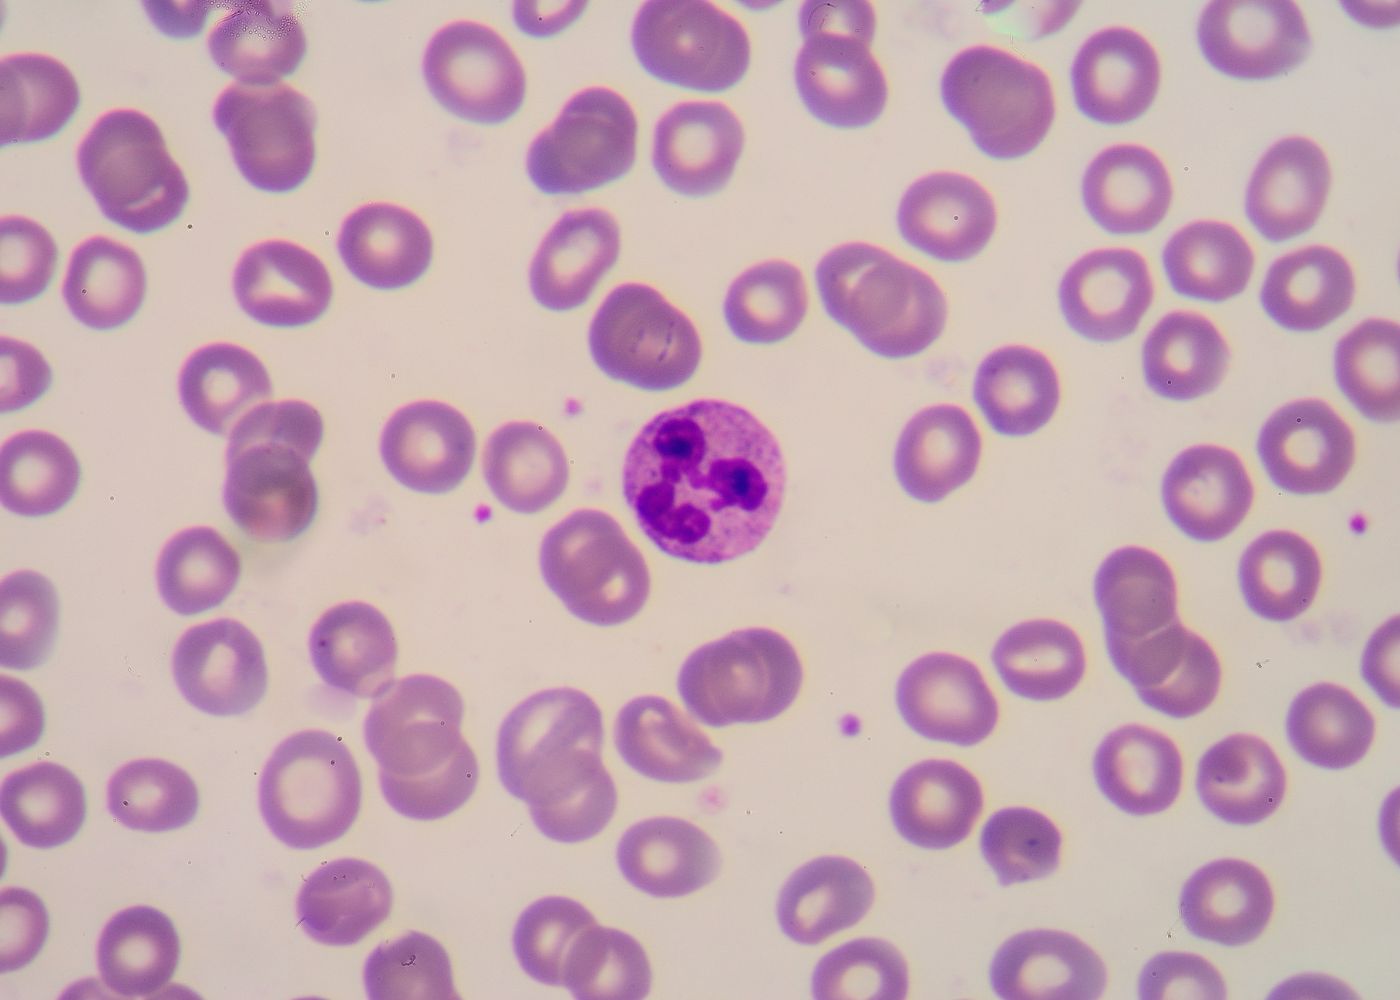

FROTIS DE SANGRE PERIFÉRICA (CUENTA DIFERENCIAL)
Examina bajo el microscopio una muestra de sangre para evaluar la apariencia y el número de células sanguíneas, especialmente los glóbulos blancos. Esta prueba ayuda a identificar y diagnosticar diversas enfermedades de la sangre, así como problemas que afectan a la sangre y a otros sistemas del cuerpo.
Detalles de análisis
Indicaciones
Ayuno de 2 horas.
Procedimiento
Se le tomará una muestra sanguínea.
Tiempo de entrega
Mismo día por la tarde.
Genetic Testing
¿Tienes alguna duda?
Consulta las dudas más frecuentes o comunicate con nosotros para una mejor atención
Trabajamos con la mejor tecnología y equipo para brindarte resultados certeros.
Te recomendamos acudir con tu médico para que interprete tus resultados en el contexto de tu salud. También puedes contactarnos si tienes dudas generales; nuestro equipo estará encantado de ayudarte a entender el proceso.
No siempre es necesaria una orden médica. Puedes acudir directamente para realizarte estudios básicos o de rutina. Sin embargo, algunos análisis especializados sí requieren indicación médica.